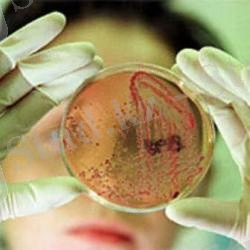
http://socialvet.ru/uploads/images/00/00/77/2013/03/23/96659bc798.jpg

Ветеринариялық практикадағы бруцеллезді серологиялық анықтаудың әдістері мен диагностикасы


Қазақстан Республикасы Ғылым және Білім министірлігі
Семей қаласындағы Шәкәрім атындағы мемлекеттік университеті
бөж
Тақырыбы. бруцеллезді серологиялық анықтау
Орындаған: Ақжолов. Е. Н
Тексерген: Нуркенова. М. К
Семей 2015жыл
ЖОСПАР:
І. Кіріспе
ІІ. Негізгі бөлім
Бруцеллезді серологиялық анықтау
ІІІ. Қорытынды
ІV. Қолданылған әдебиеттер

Кіріспе
Бруцеллез (brucellessis ) - жануарлар мен адамдарда болатын созылмалы жұқпалы ауру. Көптеген жануарларда іш тастаумен және шуы түспеумен, ені қабынумен, өмір сүру қабілеті жоқ төлдердің тууымен және қысырлықпен байқалады. Бруцеллездің қоздырғыштары 1866 жылы ешкілер мен қойлардың мальта безгегі (Brucella melitensis) ауруына себеп болған ешкі сүтінде табылған бактерияларды анықтаған Д. Брюс атымен аталған Brucella тобы болып табылады. Бруцеллез әлемнің көптеген елдерінде - Африкада, Орталық және Оңтүстік Америкада, Азия және Еуропаның, оның ішінде ТМД-ның кейбір елдерінде (Украина, Ресей, Қазақстан) кең таралған. Экономикалық зияны дұрыс төл алмаудан (іш тастаулар 60% жануарларда тіркеле алады), қысырлық, өндірімділіктің төмендеуі, карантиндық іс-шараларды өткізуге жұмсалатын үлкен шығындардан құралады.
Бруцеллезды аныктау . Бруцеллезге ұшыраған жануарларды дер кезінде анықтаудың бұл қауіпті ауруды жоюда маңызы орасан үлкен. Бруцеллез диагностикасын қою үшін бактериоскопия жасалады, бруцелла культурасы бөлініп алынады, лабораториялық жануарларға биологиялық сынақ жүргізіледі, ал жаппай зерттеуге иммунобиологиялық әдістер қолданылады.
Серологиялық реакциялардан бруцеллез диагностикасын қоюға ең жиі қолданылатыны агглютинация, комплементті байланыстыру реакциялары.
Агглютипацияның пробиркалық реакциясын түбі біркелкі дөңес пробиркаларға төрт түрлі сұйытылған 1 мл мөлшерінде жасайды. Шошқа, кой, ешкі, бұғы, ит қан сарысулары 1:25, 1:50, 1:100, 1:200 қатынасында; сиыр, жылкы және түйе қан сарысулары 1:50, 1:100. 1:200, 1:400 катынасында сұйытылған түрінде алынады. Жаппай зерттеулерде АР-сын сұйытылған түрінде жасауға болады, бірақ бұлай еткенде, он нәтижс берген реакцияларды төрт сұйытылған түрінде кайта тексереді.
Шошка, кой, ешкі, бұгы жэне ит кан сарысуында 1:50 катынасында ал сиыр, жылкы, түйе үшін 1:100 және одан артық сұйытылған жағдайда агглютинация жүрсе реакция оң деп саналады. Шошка, кой, ешкі, бұғы және ит 1:25 катынасында және сиыр, жылқы, түйе 1:50 қатынасындан сұйытылған кан сарысуында ғана агглютинация реакциясы жүрсе күмәнді реакция болады. Күмәнді реакцияда жануардың кан сарысуын 3-4 аптадан кейін кайта зерттейді. Бруцеллез каупі бар фсрмадағы малдарды кайтадан зерттегенде күмәнді АР кайтадан кайталаған жағдайда реакция оң деп саналады.
Соматикалық антигендер - грам - теріс бактериялардың қабырғасындағы липополисахаридтердің бүйірін бойлай орналасып, жасушалардың бетіне шығып тұратын аолисахаридтердің тізбектері. Бұл тізбектер іс жүзінде бактериялардың детерминанталары болып табылады. Кейінгілердің ұқсастықтарына қарай сальмонеллалар мен эшерихиялар О - топтарға біріктірілген. К - антигендер әдетте соматикалық антигендерді қалқандап тұрады, сондықтан о - антигендерді анықтау үшін зерттеуге алынған бактерияларды алдын ала температуралық өңдеуден өткізу керек.
Н - антигендер . Жылжымалы қасиеті бар бактериялардың Н - антигендері немесе қылша антигендері болады. Қылшалар ыстыққа төзімсіз белокты кешеннен құралады. Грам теріс бактериялардың толық антигендік формуласы О : Н : К тізбегі түрінде жазылады. Микроб өсіндісінің антигендік құрылымының анықтау мақсатында агглютинирлеуші монорецепторлы диагностикалық қан сарсуларының жиынтығы қолданылады.
Шартты патогендік қасиеті бар бактерияларды табу және оларды ажырату.
Тамақ арқылы тарайтын уытты індет қоздырушылары организмде, сыртқы ортада көптеп кездеседі. Бұл бактериялар белгілі бір жағдайда ғана ауру туғызады. Сондықтан бұларды шартты ауру тудырушылар деп те атайды. Бұл топқа протей және ішек таяқшасын жатқызады.
Ішек таяқшасы қазіргі жіктелуі бойынша Escherihia туыстығына жатады. Бұл микробтардың бір ғана түрі бар деп есептелінеді, ол E. Coli немесе ішек таяқшасы. Бірақ олардың бір - бірінен серологиялық қасиеттерімен ажыратылатын көптеген типтері болуы мүмкін. Ішек таяқшасының О, К және Н үш антигені бар. О - соматикалық антиген, температураға тұрақты, К- қабықты олар (L, A) және В антигендер болып бөлінеді. Ал Н антигенді жіпшелер антигені температураға тұрақсыз, көбінесе белоктан тұрады. Ішек таяқшалары ішінен, ауру тудыратын, шартты ауру тудыратын және адамға пайдалы серотиптері кездеседі. Пайдалы ішек таяқшалары В және К витаминдерін өңдіруге қатысады, сонымен қатар бұл бактериялар іш ауру, жамандат, ж. б. қоздырушыларының, өсуіне кедергі жасайтын қасиеті бар. Ішек таяқшаларының биохимиялық қасиеттері жоғары. Олар лактозаны, глюкозаны, маннитті, малтозаны, декстрозаны, галактозаны және ксилозаны ыдыратады, желатинді сұйылтады, нитраттан нитрит түзеді, көпшілігі индол түзеді. Ішек таяқшаларын бөлу үшін Эндо, Плоскирев, Левин коректік орталары пайдалынады. Эндо агарында E. Coli жалтыраған қызыл түсті шоғырлар түзеді және ортаның да түсін өзгертеді. Левин агарында олар қара көкшіл, ал Плоскирев агарында қоңыр қызыл шоғыр түрінде өседі. Жұғындыда Грам әдісімен боялмайтын, таяқшаның болуы, ал коректік орталарда шоғырлардың болуы және олардың мочевинаны ыдыратпауы, күкіртті сутек түзбеуі, индол түзілуі етте ішек таяқшасының бар екендігін көрсетеді.
Proteus туыстасына жататын бактериялар жылдам қозғалатын, Грам әдісімен боялмайтын таяқша. Биохимиялық қасиеттеріне байланысты Protei тобын бірнеше түрге бөледі: Pr. vulqaris, Pr. nirabilis, Pr. morqani, Pr. rettqeri. Ал Кауфман және Перч антигеннің құрылымына қарай, олардың бірнеше серотиптерін ажыратады. Протейдің негізгі ерекшеліктеріне олардың барлық түрлерінің мочевинаны ыдырату қасиеті жатады. Олар желатинаны да сұйылтады, ал лактозаны, маннитті ыдыратпайды. Индол, сутекті күкіртті түзуі өзгеріп отырады. . Қатты қоректік ортада протей жайылып өскен шоғыр түрінде кездеседі. Бірақ, кейде, орта көлемде мөлдір ортасы қызғылт болып келетін қозғалмайтын түрі де кездеседі. Еттен протейді бөлу үшін ( Н - түрін ), Шукевич әдісі, ал қозғалмайтын (О - түрін) протейді анықтау үшін Плоскирев әдісі қолданылады. Бұл ортада өзіндік иісі бар мөлдір, шоғыр түрде өседі. Шар тәрізді бактерияларды (кокктарды) ажырату. Ауру тудыратын шар тәріздес бактериялар Micrococcoceae класына, Schisemyceates және Schisemyceates тұқымдастарына, және Staphylococus туыстығына жатады. Тамақтан болатын улануда бұл бактериялардың да маңызы зор. Шар тәріздес микробтар табиғатта өте кең тараған. Олар ауада, топырақта, суда, мал, адам терісінде, тыныс алу жолдарында және ас қорыту жүйесінде көптеп кездеседі. Қатты коректік ортада өскенде пайда болатын шоғырдың түсіне байланысты ақ, сары және алтын түстес стафилакокктардың көптеген серологиялық түрінің ішінде адамға және малға қауіпті болып табылатындары: Str. haemoliticus, str. viridans, str. faecalis жатады. Стафилакокктар мен стрептококктар аэробты немесе факултативті анэробты микробтар.
... жалғасы- Іс жүргізу
- Автоматтандыру, Техника
- Алғашқы әскери дайындық
- Астрономия
- Ауыл шаруашылығы
- Банк ісі
- Бизнесті бағалау
- Биология
- Бухгалтерлік іс
- Валеология
- Ветеринария
- География
- Геология, Геофизика, Геодезия
- Дін
- Ет, сүт, шарап өнімдері
- Жалпы тарих
- Жер кадастрі, Жылжымайтын мүлік
- Журналистика
- Информатика
- Кеден ісі
- Маркетинг
- Математика, Геометрия
- Медицина
- Мемлекеттік басқару
- Менеджмент
- Мұнай, Газ
- Мұрағат ісі
- Мәдениеттану
- ОБЖ (Основы безопасности жизнедеятельности)
- Педагогика
- Полиграфия
- Психология
- Салық
- Саясаттану
- Сақтандыру
- Сертификаттау, стандарттау
- Социология, Демография
- Спорт
- Статистика
- Тілтану, Филология
- Тарихи тұлғалар
- Тау-кен ісі
- Транспорт
- Туризм
- Физика
- Философия
- Халықаралық қатынастар
- Химия
- Экология, Қоршаған ортаны қорғау
- Экономика
- Экономикалық география
- Электротехника
- Қазақстан тарихы
- Қаржы
- Құрылыс
- Құқық, Криминалистика
- Әдебиет
- Өнер, музыка
- Өнеркәсіп, Өндіріс
Қазақ тілінде жазылған рефераттар, курстық жұмыстар, дипломдық жұмыстар бойынша біздің қор #1 болып табылады.



Ақпарат
Қосымша
Email: info@stud.kz